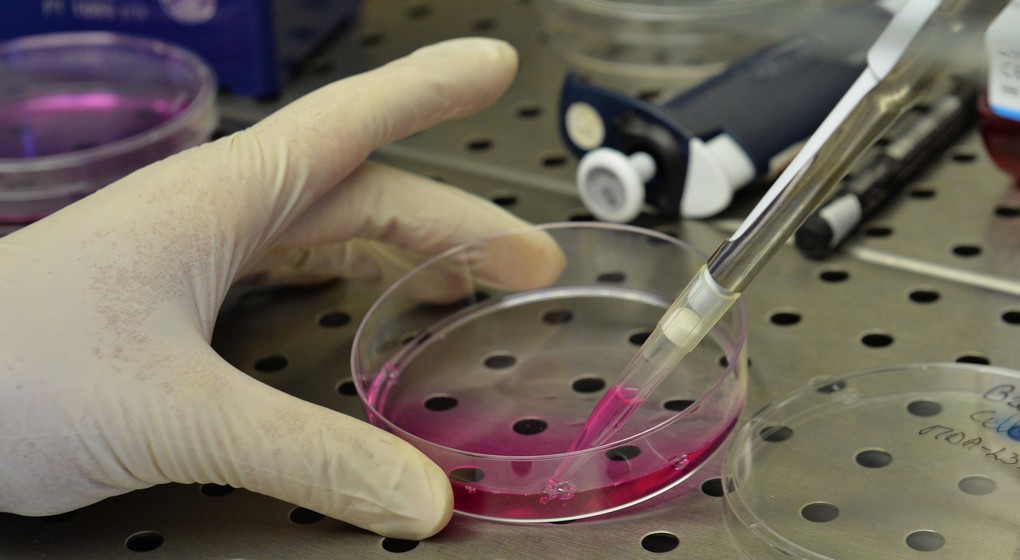

Seule la moitié des femmes se font dépister tous les 3 ans contre le cancer du col de l’utérus
Seule la moitié des femmes belges se font dépister contre le cancer du col de l’utérus au moins tous les trois ans, comme recommandé, ressort-il d’un sondage mené auprès d’un millier de femmes à l’initiative de l’entreprise pharmaceutique MSD. Pourtant, en Belgique, le frottis est intégralement remboursé tous les trois ans pour les femmes entre 25 et 65 ans.
“Dans notre pays, seule la moitié des femmes se font contrôler tous les trois ans soit parce qu’elles n’aiment pas aller chez le médecin soit par manque de temps“, pointe MSD, qui publie les résultats alors que le mois de janvier a été choisi par l’Organisation mondiale de la santé (OMS) comme mois de sensibilisation à la prévention de cette maladie.
Si la plupart des femmes connaissent la cause du cancer du col de l’utérus – HPV ou papillomavirus humain –, elles sont par contre “insuffisamment informées sur la vaccination et les autres moyens de prévention“, relève par ailleurs l’étude. La moitié des femmes interrogées pensent ainsi qu’il n’est pas pertinent de se faire vacciner après un certain âge.
Chaque année, quelque 600 femmes belges sont diagnostiquées avec un cancer du col de l’utérus, “même si de nombreux cas pourraient être évités grâce au dépistage“, souligne Peter van Dam, oncologue à l’hôpital universitaire d’Anvers.
“La vaccination et le dépistage sont nos armes les plus importantes dans la lutte contre les cancers liés au HPV“, conclut le spécialiste.
En Belgique, la vaccination contre le HPV est gratuite pour les jeunes de moins de 18 ans.
Belga – Photo : Belga / David Stockman